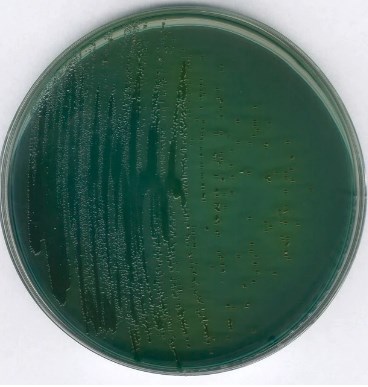

Description
Synonyms: TCBS Agar, Thiosulfate Citrate Bile Salts Sucrose Agar, Vibrio Selective Agar
General description
Thiosulfate citrate bile salts sucrose (TCBS) Agar uses an alkaline pH (8.6), ox bile and 1% NaCl to prevent the growth of gram positive bacteria, members of the Enterobacteriaceae family and the genus Pseudomonas.
Application
Thiosulfate citrate bile salts sucrose (TCBS) Agar is a selective agar for the isolation and cultivation of Vibrio cholerae and other Vibrio species.
Preparation Note
Dissolve 88 g in 1 litre distilled water and bring to the boil. Pour plates. Do NOT autoclave.
Application
GranuCult® prime Thiosulfate Citrate Bile Sucrose (TCBS) Agar is used to isolate and differentiate Vibrio spp. and other enteropathogenic microorganisms from products intended for human consumption, animal feed, environmental samples in the production area, food production, food handling, and other materials.
Properties
agency
ISO 21872
Pack Size
500g
form
powder
technique(s)
microbiological culture: suitable
pH
8.6±0.2 (25 °C)
application(s)
food and beverages
pharmaceutical
storage temp.
15-25°C
suitability
selective and differential for Vibrio spp.
Analysis Note
- The dehydrated medium is a granulate with green color.
- The prepared medium is clear to slightly opalescent and blue-green.
Legal Information
GRANUCULT is a registered trademark of Merck KGaA, Darmstadt, Germany
NutriSelect is a registered trademark of Merck KGaA, Darmstadt, Germany
![Oxidase Test Strips [Pack of 100]](https://idealmedical.co.za/wp/wp-content/uploads/2020/05/023-Bactident-oxidase-strips-300x300.jpg)


![ReadyPlate™55 Kit Chromocult® m-Green Agar [Pack of 150]](https://idealmedical.co.za/wp/wp-content/uploads/2020/05/027-Agar-plates-300x300.jpg)
Reviews
There are no reviews yet.